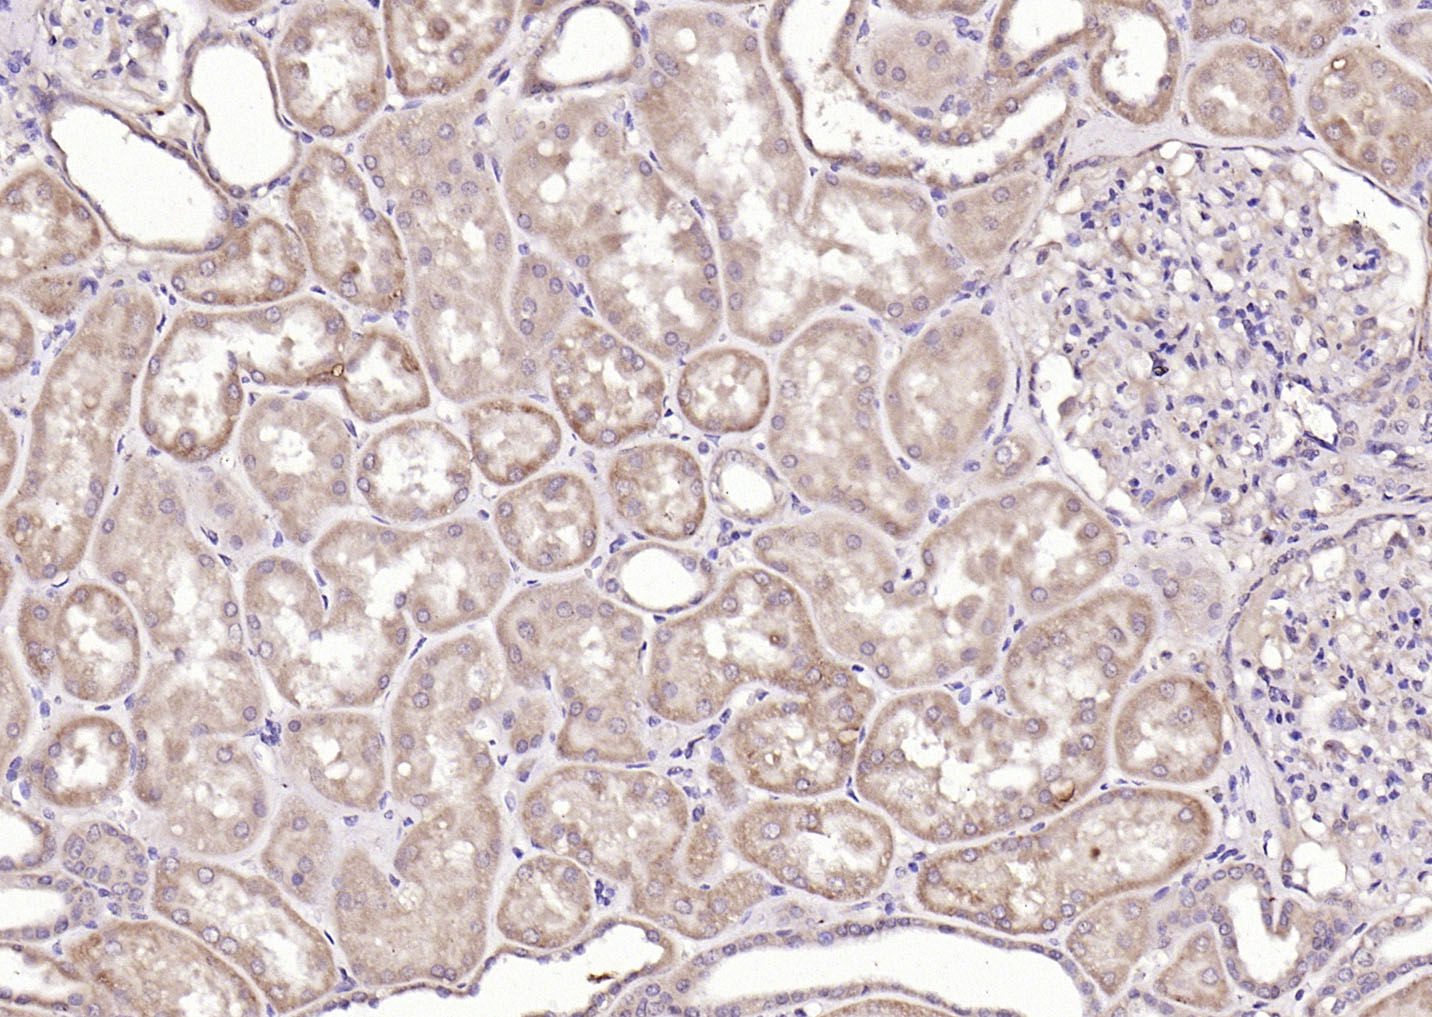
产品细节图片3

相关产品推荐更多 >

SOX10 Rabbit pAb(bs-20563R)-50ul/100ul/200ul
¥1180
phospho-MEF2A (Thr319) Rabbit pAb(bs-5485R)-50ul/100ul/200ul
¥1180
RBX1 Rabbit pAb, HRP conjugated(bs-8391R-HRP)-100ul
¥2980
ADAR1 Rabbit pAb, Biotin conjugated(bs-2168R-Bio)-100ul
¥2980
Complement component C9b Rabbit pAb(bs-15307R)-50ul/100ul/200ul
¥1180
万千商家帮你免费找货
0 人在求购买到急需产品
- 详细信息
- 文献和实验
- 技术资料
- 应用范围:
产品信息以Bioss网站为准
- 规格:
50ul/100ul/200ul
| 规格: | 50ul | 产品价格: | ¥1180.0 |
|---|---|---|---|
| 规格: | 100ul | 产品价格: | ¥1980.0 |
| 规格: | 200ul | 产品价格: | ¥2800.0 |
| 产品编号 | bs-10523R |
| 英文名称 | Cathepsin L(heavy chain) Rabbit pAb |
| 中文名称 | 组织蛋白酶L抗体 |
| 英文别名 | Cathepsin L; Major Excreted Protein; Cathepsin L1; EC 3.4.22.15; CTSL1; MEP; EC 3.4.22; CATL; CATL1_MOUSE; |
| 产品应用 | WB=1:500-2000, IHC-P=1:100-500, IHC-F=1:100-500, IF=1:100-500 Not yet tested in other applications. |
| 交叉反应 | Human, Mouse (Rat) |
| 抗体来源 | Rabbit |
| 免疫原 | KLH conjugated synthetic peptide derived from mouse Cathepsin L |
| 亚型 | IgG |
| 性状 | Liquid |
| 纯化方法 | affinity purified by Protein A |
| 克隆类型 | Polyclonal |
| 理论分子量 | 19/37 kDa |
| 浓度 | 1mg/ml |
| 储存液 | 0.01M TBS (pH7.4) with 1% BSA, 0.02% Proclin300 and 50% Glycerol. |
| 研究领域 | Cell Biology > Proteolysis / Ubiquitin > Proteolytic enzymes > Cysteine protease > Cathepsins Neuroscience > Cell Adhesion Proteins > Membrane Proteins Signal Transduction > Cytoskeleton / ECM > Extracellular Matrix > ECM Enzymes > Other Enzymes |
| 亚基 | Dimer of a heavy and a light chain linked by disulfide bonds (Probable). Interacts with Long isoform of CD74/Ii chain; the interaction stabilizes the conformation of mature CTSL (PubMed:11483509, PubMed:12417635). |
| 亚细胞定位 | Lysosome. |
| 组织特异性 | Expressed in thymus, kidney and liver (PubMed:9545226). |
| 翻译后修饰 | During export along the endocytic pathway, pro-CTSL undergoes several proteolytic cleavages to generate the CTSL single-chain and two-chain mature forms, composed of a heavy chain linked to a light chain by disulfide bonds (PubMed:11483509). |
| 相似性 | Belongs to the peptidase C1 family. |
| 功能 | Thiol protease important for the overall degradation of proteins in lysosomes (Probable). Involved in the solubilization of cross-linked TG/thyroglobulin and in the subsequent release of thyroid hormone thyroxine (T4) by limited proteolysis of TG/thyroglobulin in the thyroid follicle lumen (PubMed:12782676). |
| 保存条件 | Shipped at 4℃. Store at -20℃ for one year. Avoid repeated freeze/thaw cycles. |
| 注意事项 | This product as supplied is intended for research use only, not for use in human, therapeutic or diagnostic applications. |
| 背景资料 | The protein encoded by this gene is a lysosomal cysteine proteinase that plays a major role in intracellular protein catabolism. Its substrates include collagen and elastin, as well as alpha-1 protease inhibitor, a major controlling element of neutrophil elastase activity. The encoded protein has been implicated in several pathologic processes, including myofibril necrosis in myopathies and in myocardial ischemia, and in the renal tubular response to proteinuria. This protein, which is a member of the peptidase C1 family, is a dimer composed of disulfide-linked heavy and light chains, both produced from a single protein precursor. At least two transcript variants encoding the same protein have been found for this gene. |
| 应用 | 推荐稀释比例 |
| {WB} | {1:500-2000} |
| {IHC-P} | {1:100-500} |
| {IHC-F} | {1:100-500} |
| {IF} | {1:100-500} |


Lane 1: Mouse Liver tissue lysates
Lane 2: Mouse Kidney tissue lysates
Primary: Anti-Cathepsin L(heavy chain) (bs-10523R) at 1/1000 dilution
Secondary: IRDye800CW Goat Anti-Rabbit IgG at 1/20000 dilution
Predicted band size: 19/37 kDa
Observed band size: 40 kDa
风险提示:丁香通仅作为第三方平台,为商家信息发布提供平台空间。用户咨询产品时请注意保护个人信息及财产安全,合理判断,谨慎选购商品,商家和用户对交易行为负责。对于医疗器械类产品,请先查证核实企业经营资质和医疗器械产品注册证情况。
 文献和实验
文献和实验【资源】全面归类网址:毕赤酵母表达各种来源蛋白(细菌,真菌,植物,人类等)
A, B and C neurotoxinI453Clostridium botulinum neurotoxin (BoNT) serotype A and BI, 78 mg/L[57]Clostridium botulinum neurotoxin, serotype AI, 450 mg/kg cells308Clostridium botulinum neurotoxin heavy chain fragment, serotype BI, 390 mg/g[58]Clostridium
by staining in simple IHC the relevant heterologous primary antibodies. E.g. many goat anti mouse IgG1 heavy chain do stain rat IgG2a and IgG2b . Procedure: First stain HRP Developing solution Second stain AP
IgG 1 heavy chain do stain rat IgG 2a and IgG 2b . Procedure: Apply the correct procedure (fixation or antigen retrieval) to the sections
 技术资料
技术资料暂无技术资料 索取技术资料






